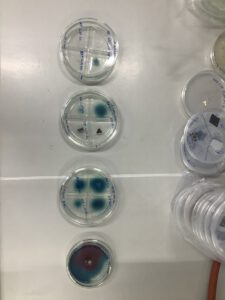

Am nächsten Freitag, den 27. Februar, wird unsere Schülerin Sophie Pfeifer auf dem Regionalwettbewerb von „Jugend forscht“ ein ganz besonderes Projekt vorstellen. Wer sie kennt, weiß, dass Sophie mit Leidenschaft Biologie betreibt (auch schon auf Uni-Niveau) und vor allem Pilze liebt. Ihr Projekt ist topaktuell und trägt den Titel „Von Plastik fressenden Pilzen zu einer sich selbst leerenden Mülltonne“. Dankenswerterweise hat die Mikro-Biologie der RWTH Aachen ihr dazu die Türen geöffnet und in dortigen Labor experimentieren lassen, welche Pilze unter welchen Bedingungen wie effektiv Plastik abbauen.
Sophie hat im Januar eine wissenschaftliche Arbeit zu ihrem Projekt abgegeben und sich damit für die Teilnahme am Regionalwettbewerb qualifiziert. Am Wettbewerbstag wird sie an ihrem selbst gestalteten Stand ihre Forschungsansätze, -methoden und -ergebnisse präsentieren und im Jury-Gespräch WissenschaftlerInnen Rede und Antwort stehen. Seit Abgabe der Arbeit hat Sophie weitergeforscht und kann mit neusten Erkenntnissen auftrumpfen. Wir drücken ihr fest die Daumen.
Bastian Joppich, Christiane Lehmler und die Couven-Gemeinschaft